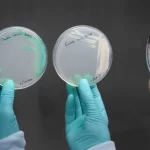

Mais de vinte aves migratórias mortas foram encontradas no litoral do Rio Grande do Norte nesta semana. A informação foi repassada pelo Governo do Rio Grande do Norte na tarde desta quarta-feira (24) através de nota conjunta assinada pela Defesa Civil, Idiarn, Idema, Sesap e Assecom.
Segundo o Governo, devido ao decreto de estado de emergência zoossanitária, emitido nesta segunda-feira (22) pelo Ministério da Agricultura e Pecuária, em função da detecção da infecção pelo vírus da influeza aviária H5N1 de alta patogenicidade (IAAP) em aves silvestres no Brasil, foram recolhidas e enviadas amostras dos animais encontradas no RN para análise do Laboratório Federal de Defesa Agropecuária-LFDA/SDA.
Não há confirmação de contato de seres humanos com as aves encontradas no litoral. As autoridades sanitárias também não registram ocorrência de casos suspeito ou confirmado de gripe aviária. Os órgãos responsáveis seguem acompanhando a situação, com as devidas ações de vigilância e rastreio.
As autoridades pedem que as pessoas que eventualmente tiveram contato com aves encontradas mortas ou doentes em área litorânea coloquem-se automaticamente em isolamento por dez dias e contatem um serviço de saúde da sua região.
O Governo do Estado também indica as seguintes recomendações:
- Não tocar, recolher, resgatar ou receber aves mortas ou doentes em área litorânea;
- Caso encontre alguma ave nestas condições: doentes (cambaleantes) ou mortas, ligar para (84) 99668.3185 – Diretoria de Defesa e Inspeção Sanitária Animal – disaidiarn@gmail.com
- Cuidado com fontes de informações não confiáveis. Em caso de qualquer dúvida, consultar canais e perfis oficiais para checar a informação
- Repasse essa informação aos frequentadores de praias, funcionários de hotéis, pescadores, moradores e demais envolvidos
TCM Notícia

One Comment
Leave a ReplyOne Ping
Pingback:Aves mortas encontradas no litoral potiguar não estavam com H5N1, aponta exames – MOSSORÓ NEWS